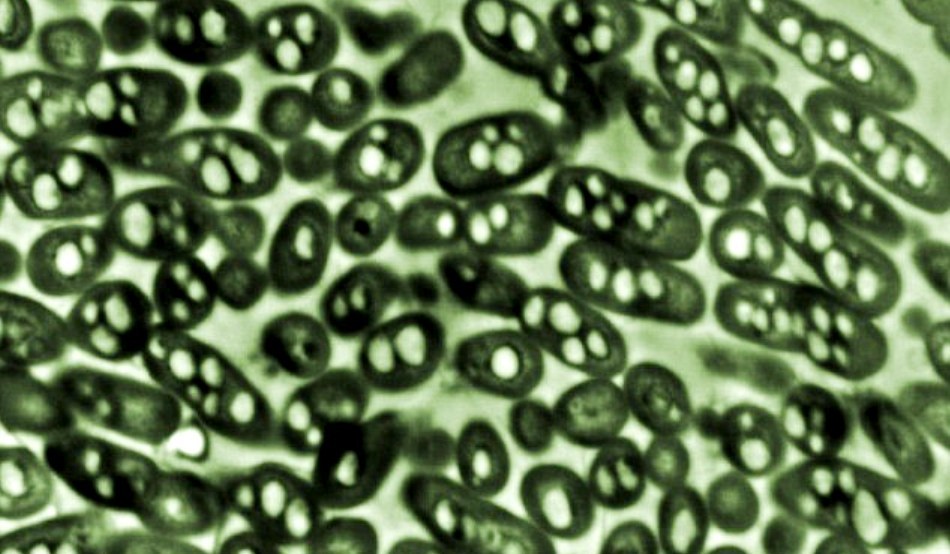
Bacteria Ralstonia eutropha

Mulţumită specialiştilor de la MIT, care au modificat genetic o bacterie din sol numită Ralstonia eutropha, în viitor va fi posibil să ne alimentăm maşinile folosind deşeuri menajere. Atunci când este supusă condiţiilor de stres, bacteria nu mai creşte şi îşi concentrează toată energia pentru a crea compuşi complecşi pe bază de carbon.
Oamenii de ştiinţă de la MIT au manipulat genele bacteriei pentru a o determina să producă combustibil sub forma unui alcool numit izobutanol, care poate fi utilizat singur sau amestecat cu benzina. Mai mult, cercetătorii care lucrează la proiect speră să reuşească să transforme şi dioxidul de carbon, emis de vehicule şi instalaţii industriale, în combustibil.
Coordonatorul proiectului, Christopher Brigham, a explicat că, în starea sa naturală, atunci când sursa sa de nutrienţi esenţiali (nitrat şi fosfat) devine insuficientă, bacteria stochează carbon. Cu alte cuvinte ea reţine hrană pentru mai târziu, când resursele vor fi mai limitate. „Reţine carbonul disponibil şi îl stochează sub forma unor polimeri care au proprietăţi asemănătoare cu multe dintre materialele plastice pe bază de petrol”.
Pentru a determina bacteria să producă combustibil în loc de plastic, oamenii de ştiinţă i-au dezactivat câteva gene, i-au implantat o alta de la un organism diferit şi au adus îmbunătăţiri la nivelul altor câteva gene. În urma testelor, s-a observat că microbul are potenţialul de a transforma aproape orice sursă de carbon, inclusiv deşeuri agricole sau menajere, în combustibil. În laborator, de exemplu, microbii au folosit fructoză drept sursă de carbon.
Acum, cercetătorii crează bioreactoare pentru a extinde procesul la nivel industrial. Spre deosebire de alţi biocombustibili propuşi, izobutanolul poate fi utilizat pentru motoarele actuale fără ca acestea să aibă nevoie de modificări majore. Mai mult, el a fost deja utilizat în cazul maşinilor de curse.
Sursa: Daily Mail